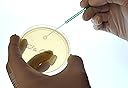
Thumbnail 3

We remain fully operational. Our teams are working around the clock to ensure your deliveries continue safely.
Copyright © 2025 Desertcart Holdings Limited

Ideal for streaking plates and obtaining inoculum
Trustpilot
5 days ago
2 days ago
2 months ago
1 month ago